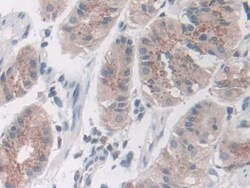
Invitrogen Nidogen 2 Polyclonal Antibody, Invitrogen:Antibodies:Primary

missing translation for 'onlineSavingsMsg'
Learn More
Learn More
Invitrogen™ Nidogen 2 Polyclonal Antibody, Invitrogen™


Rabbit Polyclonal Antibody
€ 189.00 - € 401.00
Specifications
| Antigen | Nidogen 2 |
|---|---|
| Concentration | 0.5 mg/mL |
| Applications | Immunohistochemistry (Paraffin), Western Blot |
| Classification | Polyclonal |
| Conjugate | Unconjugated |
| Product Code | Brand | Quantity | Price | Quantity & Availability | |||||
|---|---|---|---|---|---|---|---|---|---|
| Product Code | Brand | Quantity | Price | Quantity & Availability | |||||
|
17948782
|
Invitrogen™
PA5145302 |
20 μL |
€ 189.00
20µL |
Please sign in to purchase this item. Need a web account? Register with us today! | |||||
17959532
 |
Invitrogen™
PA5145301 |
200 μL |
€ 401.00
200µL |
Please sign in to purchase this item. Need a web account? Register with us today! | |||||
Description
Basement membranes, which are composed of type IV collagens, laminins, perlecan, and nidogen, are thin pericellular protein matrices that control a large number of cellular activities, including adhesion, migration, differentiation, gene expression, and apoptosis. Basement membranes, which are composed of type IV collagens, perlecan, and nidogen, are thin pericellular protein matrices that control a large number of cellular activities, including adhesion, migration, differentiation, gene expression, and apoptosis.Specifications
| Nidogen 2 | |
| Immunohistochemistry (Paraffin), Western Blot | |
| Unconjugated | |
| Rabbit | |
| Human | |
| Q14112 | |
| 22795 | |
| Recombinant Human NID2 protein, Leu31-Ala289 (Accession #Q14112). | |
| Primary | |
| Store at 4°C short term. For long term storage, store at -20°C, avoiding freeze/thaw cycles. |
| 0.5 mg/mL | |
| Polyclonal | |
| Liquid | |
| RUO | |
| PBS with 50% glycerol and 0.05% Proclin 300; pH 7.4 | |
| AW547149; entactin 2; entactin-2; LOW QUALITY PROTEIN: nidogen-2; Ly111; Nid2; NID-2; Nidogen; nidogen 2; nidogen 2 (osteonidogen); nidogen-2; nidogen-2; LOW QUALITY PROTEIN: nidogen-2; osteonidogen | |
| NID2 | |
| IgG | |
| Antigen affinity chromatography, Protein A | |
| NID2 |
Spot an opportunity for improvement?Share a Content Correction
Product Content Correction
Your input is important to us. Please complete this form to provide feedback related to the content on this product.
Product Title